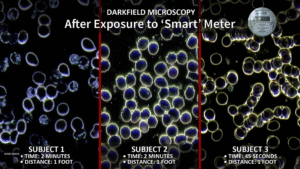

A Brief, Yet Relevant Request –
Please watch this short video, it is a bit over 2 minutes in length,
and explains in drawings anyone can understand,
why we do what we do!!!
* * * * * * *
TECHSAFE SCHOOLS LONGMONT PROUDLY PRESENTS …
Take Back Your Power – “The Smart Meter Movie.”
(It’s the one you’ve all been waiting for!)
*Disclaimer: This event is not sponsored or endorsed by the Longmont Public Library, the City of Longmont, or their affiliates.
———————————————————————————————————————————
Like sunflowers, our faces begin to turn again towards the sun as winter turns to spring; our Vitamin D levels rise and the hibernation of winter begins its thaw.

As we approach the Spring Equinox, our next event will be the seminal full-length movie on smart meters, Take Back Your Power, on March 14, 2026, as we come together to watch this film at our first Longmont Library event of the year.
An award-winning documentary about smart meters by filmmaker Josh del Sol, Take Back Your Power will be followed by community interaction which includes (fingers crossed, and weather permitting) two individuals who, themselves, were part of this movie, one of them an internationally recognized tech expert, the other, a mother who experienced the devastating loss of her son because of a cell tower, and who continues to look into cancer clusters in and around schools with towers close by.
Besides learning more about the dark side of smart meters by watching the film, there will be people at this showing who both spoke out against the smart meters coming to Longmont as well as residents whose health has been adversely impacted by AMI implementation in our community. People with relevant stories, such as the 12 individuals who had to go before city hearing boards when they refused to relinquish their electromechanical analog meters. All 12 (you know who you are!) were told “NO” to the retention of their meters, then threatened with power shutoffs. Please come to share your stories. Anyone who has experienced any adverse effects from the installation of a smart or digital opt-out meter is encouraged to attend. We’d like to know you! In addition, we want to take the temperature of our audience as to how many folks would support initiatives at a state and local level to ensure that a resident living in Colorado can keep their electromechanical analog meters, and dare we say, without penalty (ie, monthly fee!).
And dare we also say: You WANT to see this movie!!!! Yes, yes, you DO!!!
Who: TechSafe Schools Longmont presents a live community event
What: Take Back Your Power award-winning documentary
When: Sat. March 14, 2026
Time: 1:30 – 4 PM
Venue: Longmont Public Library, large conference room, easy access from west entrance on Kimbark St.
Cost: FREE public event! RSVP encouraged as seating is limited.
RSVP HERE (limited seating)
About the Film –
Take Back Your Power, an award-winning investigative documentary by Josh del Sol examines the rapid global rollout of “smart” utility meters and the hidden consequences that come with them. Moving beyond headlines and marketing claims, the film brings together whistleblowers, scientists, doctors, lawyers, government officials, and security experts to explore issues ranging from in‑home data surveillance and rising utility bills to cyber‑security risks, environmental concerns, and questions about informed consent. What begins as an inquiry into smart meters quickly expands into a broader look at how profit‑driven technological systems can quietly reshape daily life and erode personal rights under the banner-buzzwords of “smart” and “green.”
Come see Take Back Your Power for yourself; it doesn’t just raise alarms—it empowers those who view it. The film and the film-maker, through a storytelling lens, incorporate multiple interviews with experts and people whose lives have been adversely affected by this technology. Josh invites audiences to think critically about what individuals actively or passively (through lack of education and/or informed consent) invite, or allow into their lives, onto their homes and into their communities. The film offers historical context, real‑world case studies, and emerging solutions that show public engagement can make a difference. Josh has gathered together in one production, public health authorities, EMF researchers, tech experts, and people who’ve been adversely affected by wireless tech. Whether you’re concerned about digital surveillance and privacy, health effects, consumer rights, or the future of energy infrastructure, this documentary challenges assumptions and sparks informed conversation, leaving viewers better equipped to ask questions, make choices, and take part in shaping the systems that affect their lives.
Public discussion, Q/A, comments and interaction will follow the movie, which will begin promptly at 1:45 PM, after introductions. Presuming all things cooperate with us including the March weather, we will potentially have with us that day, two of the ‘interviewees’ from the movie, who just happen to live within a 45 minute drive of Longmont!!!
This is an important film!! Make sure to mark your calendar and show up. We look forward to watching it with you.
RSVP
*2nd Disclaimer: We take no responsibility for any attendee who walks away afterwards with eyes wide open. Attend at your own risk!
Please email longmont4safetech@gmail.com to ask to be added to our newsletter and notifications of upcoming events.
* * * * * * * * *
Below: Example of live blood analysis excerpted from Take Back Your Power….
Come to our live event on March 14 to see what healthy blood looks like…
(hint: NOT like this!!!)
* * * * * * * *

WHAT IS TECHSAFE SCHOOLS AND WHY SHOULD WE CARE?
TechSafe Schools is a project of the award-winning non-profit Grassroots Environmental Education. Recent studies document biological damage from radiofrequency radiation at levels below current FCC guidelines. Exposure is cumulative and additive, and children are at increased risk.
The TechSafe Schools project grew out of parental concern for children, particularly at school, with increased sensitivity to RF microwave radiation. Kids’ use of wireless devices, especially in school has grown rapidly in recent years, increasingly placing our children, for hours a day, at risk (as well as everyone else in the school environment). Our focus is the health, safety and well-being of all students in all schools. We believe the best environment for learning is a safe environment.
Emerging Science on RF Exposure Supports Caution.
Recent studies document biological damage from radiofrequency radiation at levels below current FCC guidelines. Exposure is cumulative and additive, and children are at increased risk.
The TechSafe Schools project is funded completely by individuals and private foundations with no conflicting financial interest, unlike the many and varied tech corporations who donate both money and devices/technology (primarily wireless) to our schools.
TechSafe Schools Longmont, one of approximately a dozen cities that participated in a yearlong pilot under Massachusetts For Safe Technology and Cece Doucette, is excited to present FREE educational events in Longmont and Boulder, which are entirely self-funded and have no vested interest other than to wake people up to this insidious danger. Everyone who has kids or cares about children’s well-being have “skin in the game.” People may donate to help defray the costs of printing and other expenses involved in putting on these live events.
A major part of our educational effort is the reducing of radiation exposure in school classrooms, something every school can do at low to no cost, and without affecting any tech-based learning or system performance. We are not anti-tech, we are pro safe tech!!!!
Reducing radiation exposure in school classrooms is a worthy and inexpensive goal. It is all upside with no downside.
So the question is:
Why not get hard wired?
Why not, indeed!
Please visit HERE for detailed video of the “how” of getting hard-wired in the schools.
With gratitude and credit to the originators of Tech Safe Schools,
visit the website
HERE.
* * * * * * * * *

March 2026 – Ginny Schuster and Doe Kelly on EMFs and Smart Meters –
What you don’t know CAN harm you!!!!
* * * * * * * * *

* * * * * * * * *
SOME OF TECHSAFE SCHOOLS LONGMONT’S PAST (2025) EVENTS
At the Intersection of Frequency and Calamity Lies… 5G
WHAT IS 5G AND WHY SHOULD WE CARE?

A Community Educational Event for an Engaged Citizenry
5G small cell infrastructure is expanding across Colorado—from Denver and Boulder to the canyon leading to Estes Park—Longmont may be next! Concerned citizens are invited to attend a community event exploring the implications of fifth-generation wireless technology (5G) and its potential impact on public health and the environment, including flora and fauna, birds, bees and children, and also the lack of informed consent around wireless technology.
This educational gathering will feature a “Mini-Movie Marathon” of short films by and with experts, featuring a half-hour Swedish film: “5G – The Untold Story.” Breakout discussions with audience participation and calls to action will be a critical part of the afternoon. The event aims to raise awareness and foster dialogue and action around questions that remain unanswered due to captured agencies, governments, and profit motives.
- What are microwaves and millimeter waves? Are they safe?
- What is the Precautionary Principle, and why is it being ignored?
- Where is informed consent for untested and potentially risky technologies?
- How does wireless radiation affect our kids, pets, pollinators, birds and ecosystems?
- Will our officials protect ‘we the people’ from this tech or allow even more harm to occur?
- What can we do?
Featured experts: Magda Havas, Prof. Lennart Hardell, Mona Nilsson, Claire Edwards, Prof. Olle Johansson
Date: Saturday, November 22
Time: 1:00 PM – 3:30 PM
Venue: Longmont Public Library, 409 4th Ave.
(enter at Kimbark Street Entrance)
Admission: By donation ($5 suggested but no one turned away)
Claire Edwards, former UN staff member, warns: “People’s first reaction to the idea that 5G may be an existential threat to all life on Earth is usually disbelief and/or cognitive dissonance. Once they examine the facts, however, their second reaction is often terror. We need to transcend this in order to see 5G as an opportunity to empower ourselves, take responsibility and take action.”
Scientific studies suggest alarming trends, including an 80% decline in insect populations over the past two decades and the potential loss of millions of trees to support uninterrupted 5G signaling for autonomous vehicles.
REGISTER
This event is not sponsored or endorsed by the Longmont Public Library, the City of Longmont, or their affiliates.
* * * * * * * * *
We completed our Boulder, CO July event at Unity Church of Boulder with the below mentioned screening of Resonance, Beings of Frequency, followed by a enlivened and helpful community discussion inside that beautiful venue. We have left the promo of the film up on this page in the hopes that, if you have not seen it yet you will seek it out. The movie is readily available to view on YouTube and other video platforms online. It is a “must see” and “can’t miss.”
* * * * * * * * *
August 16th zoom session with world EMF expert Prof. Olle Johansson, PhD whose recent
research includes both the disappearing bees and the Schumann Resonance:

Please go HERE for the replay of our call with Prof. Johansson.
(please visit this page for more information on Prof. Johansson’s work
and impact…and go here to see Olle J.’s letter to the City of Longmont)
* * * * * * * * *
TechSafe Schools – Longmont (TSSL)
at Unity Church in Boulder, CO presented
the Award-Winning Documentary
RESONANCE – BEINGS OF FREQUENCY
in late July, 2025.
This was the third Front Range showing in a series of special live events put on by TSSL to educate parents, grandparents, educators and others with “skin in the game” on the special risks and dangers of wireless radiation (aka non-native EMFs) to children, and the problem this invisible toxin poses.
* * * * * * * * * * * *
THE MOVIE
RESONANCE – Beings of Frequency –
A Film From UK-based filmmaker James Russell…
“The first documentary film to investigate the actual mechanisms by which mobile phone technology can cause cancer. Resonance takes a deeper look at how humanity is reacting to the most profound environmental change the planet has ever seen.”
———————————–
WATCH TRAILER HERE
The movie, in a nutshell:
“Resonance” is a compelling and eye-opening documentary that examines the historical relationship between life on Earth and natural electromagnetic frequencies. It explores the potential impact of artificial electromagnetic fields (EMFs) on pollinators, such as bees, and raises concerns about their effects on human health. The film delves into the Schumann resonance—a natural frequency that has shaped life on the planet—offering insight into how the invisible yet toxic pollution created by modern technology may be disrupting the native biological rhythms of the planet that support and maintain all life on earth.
“Resonance” warns of the harmful effects of artificial frequencies on human health as well as the environment, exposing the unintended consequences of widespread immersion in man-made wireless signals—frequencies that biological organisms never evolved with. Through a 60-year journey into independent scientific research, this 2013 documentary uncovers the mechanisms by which wireless technology may contribute to life-threatening diseases, including cancer, and highlights the risks associated with mobile phones and other wireless devices.
Why watch “Resonance – BoF“ and what is this film attempting to show us?
(How to: Protect the children? Educate ourselves? Save the pollinators? Save ourselves?)
If ever there was a time to become educated and up in arms about the deleterious effects of wireless electromagnetic radiation, it is now; in the last year, the mainstream US news reported a catastrophic decline in our commercial honeybee populations of between 62% and 95%. In our opinion, this non-native and ubiquitous emf (nnEMF) is a contributing factor in the demise of the bees. Do the math to find out how unsustainable this is for the food production here, and anywhere people depend on bees to pollinate their crops (ie, everywhere!).
* * * * * * * * * * * *
Who and what is TechSafe Schools – Longmont, and why should we care?
TechSafe Schools is a growing movement in the U.S. and other places, of citizens who are waking up to the harms of wireless technology and want to do something about it, especially insofar as protecting the most vulnerable among us, our kids. We are committed to bringing awareness of the harm that is happening to people, animals, insects and ocean life, microbes, and the environment in general that is being caused by the unfettered and often, thoughtless expansion of wireless and smart technology everywhere we all live and breathe.
TechSafe Schools – Longmont is a small group of Longmont residents participating in a year-long pilot program of ten cities under the umbrella of Massachusetts for Safe Technology and following the lead of Americans for Responsible Technology. This important program is dedicated to 1) raising awareness of wireless technology and how it may be adversely affecting children and other lifeforms, and 2) creating safe, wired learning spaces for kids where they are free to learn and thrive. The goal of this pilot is to create a shareable and working model of how a city can still use technology in its schools (and elsewhere) but at the same time keep kids safe using wired tech. We are excited to start the community conversation on this trending topic by hosting live events that include educational movies, panel discussions with Q&A, and other free presentations, online and off. Our March 30th presentation at the Longmont Library, Generation Zapped, was well attended, with three guest experts at the end, Josiah Mueller (Master Electrician, Erie, CO), Dr. Aviva Wertkin (Naturopathic doctor in Louisville, CO) and Virginia Farver (Ft. Collins concerned mom whose grown son developed a brain tumor from a nearby cell tower at his school and died). Our three experts led a very lively Q/A and discussion at the end of the meeting.
(Virginia has told the story of her son’s death by cell tower in many places, including the movie Take Back Your Power. Her research led to the finding of a cancer cluster in the very same room that led to his and others’ illness and deaths. Media refused to cover it. Read her story here.)

* * * * * * * * * * * *
LONGMONT4SAFETECH DID NOT SUCCEED IN ITS EFFORTS TO STOP SMART METERS IN LONGMONT; WE STILL, HOWEVER, ASK FOR YOUR DONATIONS TO ASSIST THE ONGOING EXPENSES THAT ACCRUE IN EDUCATING THE PUBLIC ON THE DANGERS OF SMART METERS AND WIRELESS EMFS. IF YOU ARE ABLE, PLEASE DONATE TODAY!!!!
HISTORY – WE RAISED PLEDGES OF BETWEEN $10 AND $11K TO STOP THE METERS, IN THE HOPE THAT A MAJOR NON-PROFIT WOULD COME TO ASSIST US IN LEGALLY STOPPING THE METERS COMING HERE. WHEN THE LAST U.S. ELECTION CAME, EVERYTHING CHANGED, THE NON-PROFIT’S MAIN DONORS CHANGED DIRECTIONS, AND THE SMART METERS WERE NOT TO BE STOPPED IN LONGMONT. OUR EFFORTS SUBSEQUENTLY ALSO CHANGED COURSE INTO A MOSTLY EDUCATIONAL ENDEAVOR, BUT WE STILL ACCRUE EXPENSES. WHETHER OR NOT YOU ARE ABLE TO DONATE TO THIS EFFORT, WE WILL STILL CONTINUE SPREADING THE WORD, THROUGH THIS WEBSITE, FACEBOOK PAGE, AND LIVE EVENTS, ON TOXIC TECHNOLOGY AND THE RISKS AND DANGERS IT POSES TO OUR FUTURE, THE CHILDREN. AND ALL LIFE.
YOUR DONATIONS WILL GO TO SUPPORT THIS ONGOING WORK, AND THE PEOPLE WHO HAVE BEEN EFFORTING FOR ALL OUR RIGHTS, TO SAFETY, SECURITY, AND TO BE FREE OF THE HUMAN HEALTH BURDENS THAT CONTINUE TO BE TRIGGERED BY THE UNFETTERED EXPANSION OF WIRELESS TECHNOLOGY.
ANY AMOUNT RECEIVED, LARGE OR SMALL, IS COMPLETELY APPRECIATED, AND HELPS US TO “KEEP ON KEEPIN’ ON” WITH THIS VITAL, LIFE-AFFIRMATIVE WORK.
Contact: longmont4safetech@gmail.com today if you’d like to donate. Please place the word DONATE in the subject line!

